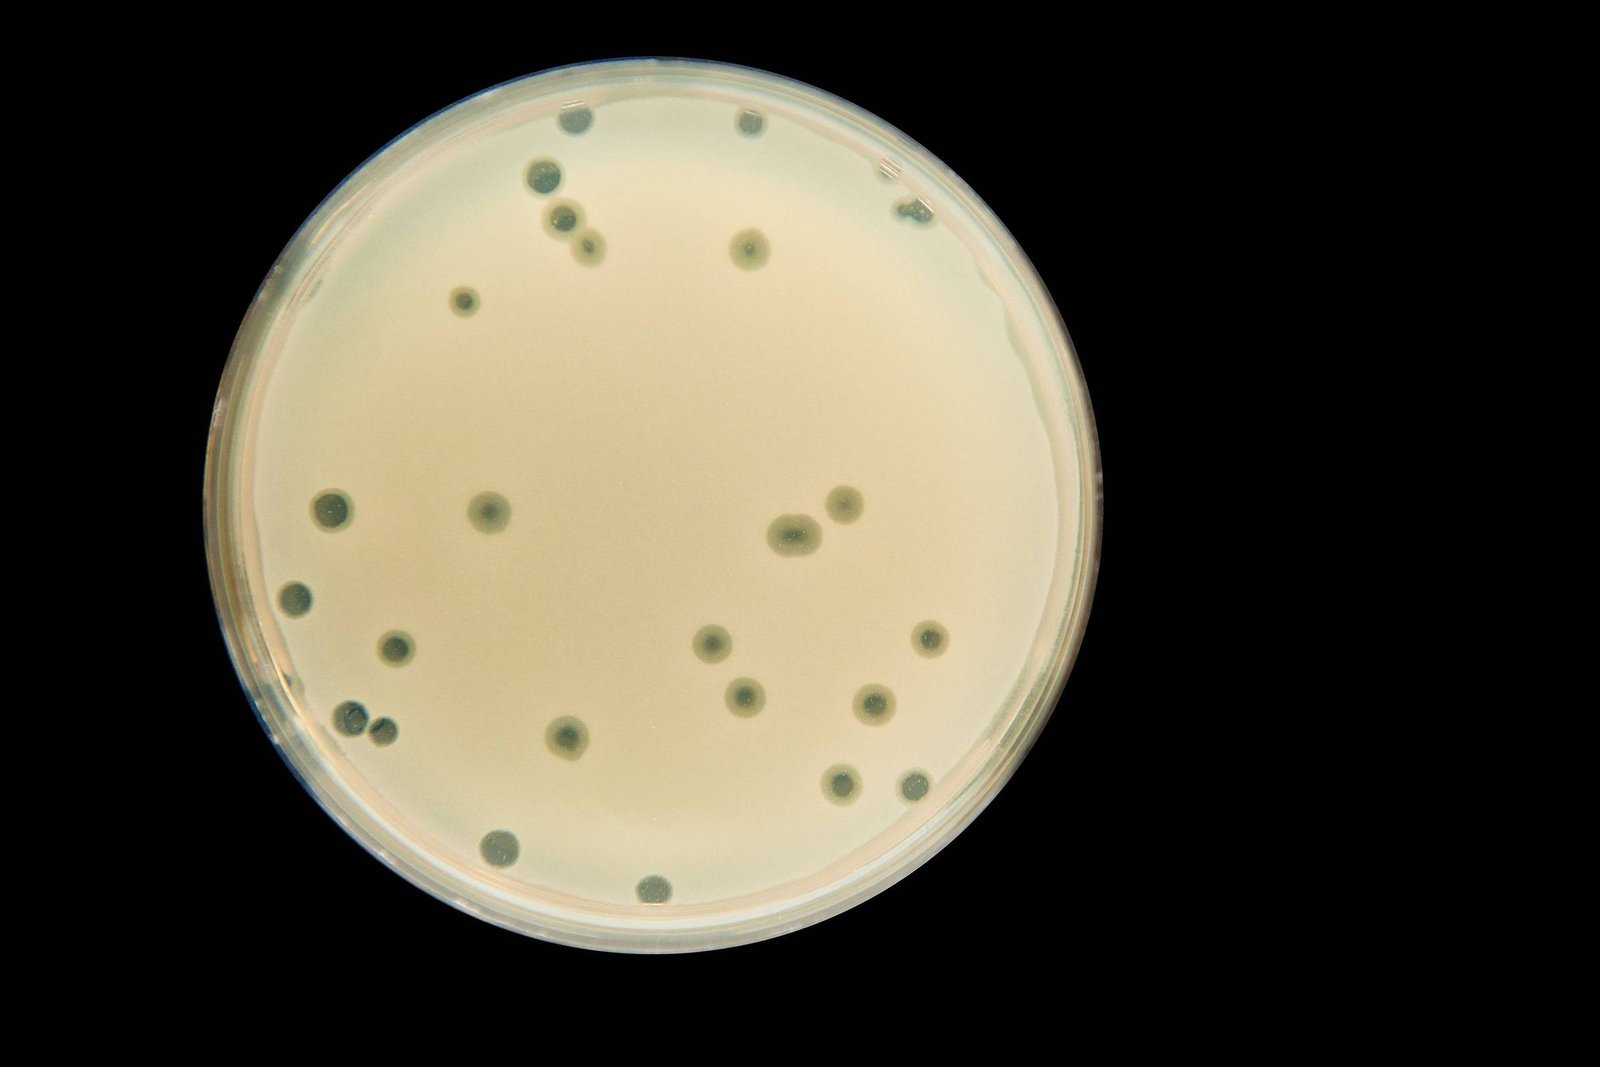
Cientistas recorrem a IA em caçada para identificar vírus - 04/03/2025 - Ciência

Carl Zimmer
Os vírus que conhecemos melhor são aqueles que nos deixam doentes, como os da gripe e os da varíola. Mas pessoas saudáveis estão repletas de vírus que não nos deixam doentes.
Os cientistas estimam que dezenas de trilhões vivem dentro de nós, embora apenas uma fração deles tenha sido identificada. A grande maioria é benigna, e alguns podem até ser benéficos. Não sabemos ao certo, porém, porque a maior parte do viroma humano ainda é um mistério.
Neste ano, cinco universidades dos Estados Unidos estão se unindo para uma caçada sem precedentes para identificar esses vírus. Elas vão coletar saliva, fezes, sangue, leite e outras amostras de milhares de voluntários. O esforço de cinco anos, chamado Programa do Viroma Humano e apoiado por US$ 171 milhões em financiamento federal, vai inspecionar as amostras com sistemas de inteligência artificial, esperando aprender sobre como o viroma humano influencia nossa saúde.
“Acho que vai superar os dados que tivemos até agora”, disse Frederic Bushman, microbiologista da Universidade da Pensilvânia e um dos líderes do programa.
As primeiras pistas do viroma humano surgiram há mais de um século. Analisando amostras de fezes, cientistas descobriram vírus conhecidos como fagos que poderiam infectar bactérias dentro do intestino. Eles também foram encontrados na boca, pulmões e pele.
Mais tarde, cientistas identificaram vírus que infectavam nossas próprias células sem causar grandes sintomas. A maioria da população mundial é infectada por citomegalovírus, por exemplo, que podem colonizar praticamente todos os órgãos.
No início dos anos 2000, novos métodos de sequenciamento genético levaram os cientistas a descobrir ainda mais vírus na saliva, no sangue e nas fezes. A tecnologia também permitiu que estimassem a quantidade de vírus em nossos corpos. Cada grama de fezes, descobriu-se, contém bilhões de fagos.
O intestino de cada pessoa pode abrigar centenas ou até mil espécies de fagos. No entanto, quando os biólogos vão de pessoa para pessoa, eles encontrarão muitas espécies virais que estão presentes em uma, mas não na outra —mesmo quando elas são casadas. Quanto mais humanos os cientistas estudam, mais espécies de fagos eles descobrem.
“Estou esperando dezenas de milhões de espécies”, disse a bióloga Evelien Adriaenssens, do Instituto Quadram em Norwich, Inglaterra.
Os fagos não estão em uma luta até a morte. Eles estão em uma parceria.
Os vírus que infectam células humanas têm se mostrado inesperadamente diversos. Em 1997, ao examinarem o sangue de um paciente, pesquisadores no Japão descobriram uma família de vírus totalmente nova que passou a ser conhecida como anelovírus. Em janeiro deste ano, um estudo revelou mais de 800 novas espécies de anelovírus, elevando o total de espécies conhecidas para mais de 6.800.
Alguns estudos recentes sobre o viroma humano levantam questões sobre a própria definição de um vírus. Um vírus padrão consiste em uma cápsula de proteína que contém genes codificados em DNA de fita dupla ou RNA de fita simples. Contudo os cientistas estão descobrindo que nossos corpos também abrigam anéis minúsculos de RNA que flutuam livremente.
Os cientistas ainda desconhecem grande parte do viroma humano. Os vírus são tão pequenos que podem se esconder dentro das células sem serem vistos. Alguns até conseguem inserir seus genes no DNA da célula hospedeira, onde podem permanecer escondidos por anos antes de se replicarem.
“Vão ter que surgir ferramentas totalmente novas”, disse a bióloga computacional Pardis Sabeti, da Escola de Saúde Pública Harvard T.H. Chan.
Sabeti e seus colegas estão desenvolvendo um sistema de IA que o Programa do Viroma Humano vai implantar para descobrir características sutis dos genes virais.
Os pesquisadores, então, tentarão descobrir o que todos esses vírus estão fazendo dentro de nossos corpos. Os cientistas tradicionalmente têm visto os fagos como predadores de bactérias, matando-as impiedosamente para fazer mais cópias de si mesmos. Entretanto, experimentos recentes sugerem uma relação muito mais complicada.
“Eles não estão em uma luta até a morte”, afirmou o microbiologista Colin Hill, do APC Microbiome Ireland, um centro de pesquisa em Cork. “Estão em uma parceria.”
No corpo humano, por exemplo, os fagos geralmente não exterminam suas bactérias hospedeiras. E as bactérias podem se beneficiar de suas relações amigáveis com os fagos, que podem transferir genes de um micróbio hospedeiro para outro, possivelmente aumentando sua sobrevivência.
Essa parceria pode ser boa para nossa saúde também. Estudos recentes sugerem que os fagos distribuem genes defensivos que seus hospedeiros podem usar para conter os patógenos invasores. E os citomegalovírus podem ajudar a nos defender contra o câncer de pele.
O imunologista Shadmehr Demehri, de Harvard, e seus colegas encontraram evidências de que os citomegalovírus se tornam ativos dentro das células da pele que foram danificadas pelo sol. As células infectadas produzem proteínas virais, que chamam a atenção das células imunes próximas. Elas atacam as células danificadas e, assim, podem impedir que progridam para o câncer.
Os estudos de Demehri mostraram que os papilomavírus humanos também podem ajudar a destruir as células da pele que estão em risco de produzir um tumor. “É uma mudança de paradigma em como pensamos sobre os vírus em geral.”